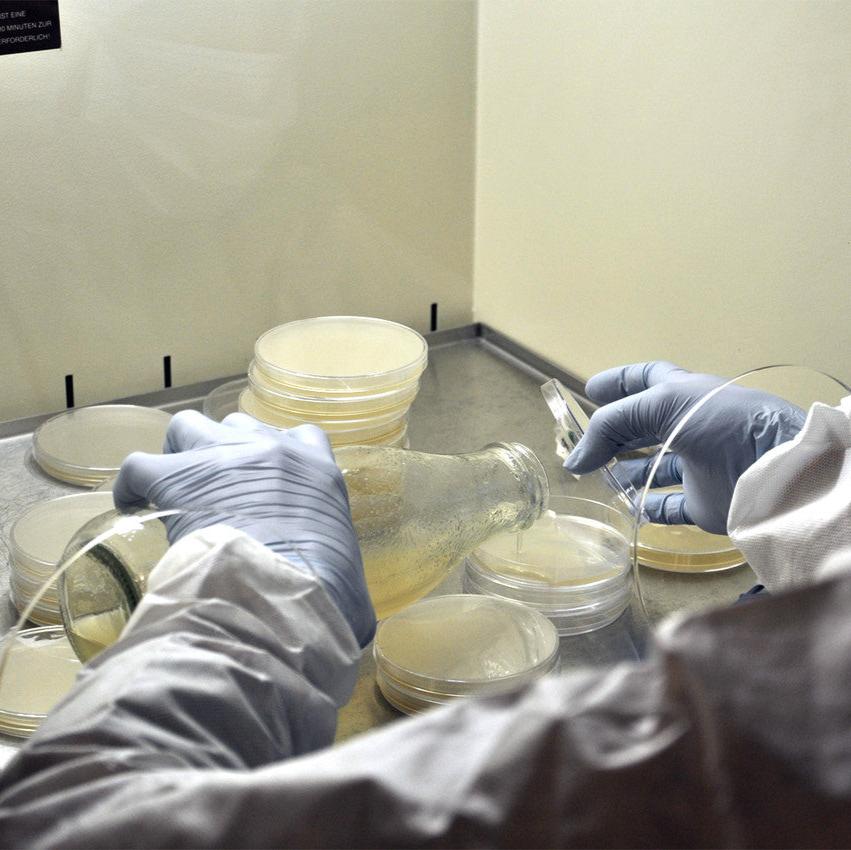
Malzextrakt-Agar - Nährboden in Petrischalen 90x14 (mm) - 5 Stück

PF-Tek Substrat (Original) - 1 Liter Reismehl & Vermiculit
Unicorn Bags 3T (Autoclave) - 0,2 µm Filterbeutel
4x Mycotainer 1200 ml - PF-Tek Dose
Gips für Pilzzucht (Calciumsulfat) - 1 kg Substrat-Zusatz
Sterilisiertes Holzsubstrat 5 L (20% Weizenkleie) – "Ready-to-Inoculate"
PF-Tek Spawn 1 Liter aus Getreidekörnern
Mikroperforierte Schlauchfolie (30 cm) - 100 µm stark
Desinfektionsmittel Pilzzucht (Antifect® N) - 500 ml
Kalk zur Pilzzucht (Calciumcarbonat) - 1 kg pH-Puffer
Strohpellets Pilzzucht (10 Liter)
Skalpellklingen aus Karbon Stahl - Fig. 10 (steril)
Pepton aus Soja (Papainisch verdaut, GVO-frei)
Parafilm M | Verschlussfolie 38m x 10cm
Hefeextrakt Pulver (Yeast Extract) - Mikrobiologie Nährboden
Impfstopfen für Mycotainer und Deckel
Geschenkgutschein - MycoGenetics Pilz-Shop
Samtfuß, Holzstielchen und Zottelmähne